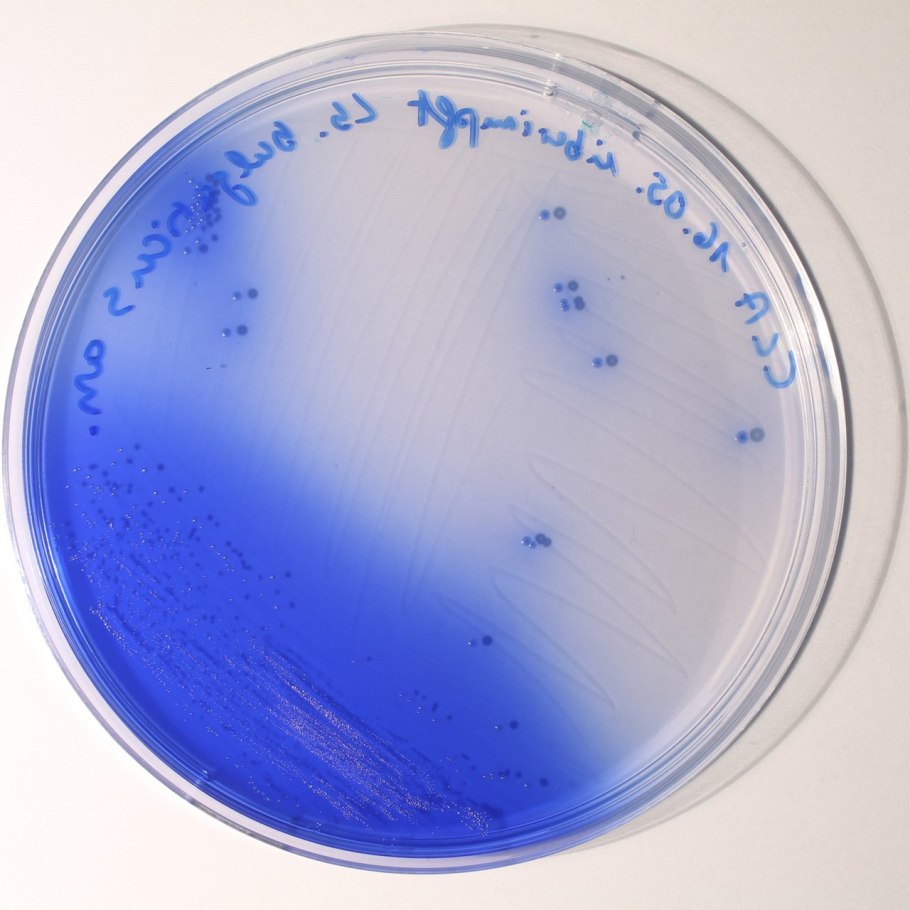
Как вырастить молочный гриб в домашних условиях с нуля

Тибетский гриб и болгарская палочка

Молочный гриб под микроскопом

Болгарская палочка Lactobacillus bulgaricus

Молочный гриб мелкие крупицы

Китайский кефирный гриб

Кефирный гриб

Кефирный гриб пробиотик

Тибетский молочный гриб кефирный показания

Индийский кефирный гриб

Болгарская палочка (Lactobacterium bulgaricum)

Комочки в кефире

Кефирный гриб

Тибетский молочный рис

Болгарская палочка Lactobacillus bulgaricus

Болгарская палочка и термофильный стрептококк

Кефирные зерна

Живые кефирные грибы

Приготовить кефирные шарики

Микрофлора тибетского гриба

Болгарская палочка и термофильный стрептококк

Йогурт бифилайф

Гриб кефирный молочный

Молочный гриб в упаковке

Гриб кефирный молочный

Лактобактерии это молочнокислые бактерии

Кефирные зерна

Йогурт с болгарской палочкой

Болгарская палочка Lactobacillus bulgaricus

Молочный гриб на черном фоне

Болгарская палочка Lactobacillus bulgaricus

Кефирный гриб

Кефирные зерна

Кефирный грибок

Лечение сахарный диабет с тибетский молочный грибок

Лактобактерии это молочнокислые бактерии

Характеристика молочного гриба

Кефирные зерна

Грамположительные стрептобациллы

Water kefir Grains

Выращивание кефирного гриба

Болгарская палочка и термофильный стрептококк

Тибетский молочный гриб в аптеке

Болгарская палочка Lactobacillus bulgaricus

Леомакс молочный гриб

Кефирный грибок

Кефирный гриб
Как вырастить молочный гриб в домашних условиях с нуля

Кефирные зерна можно съесть

Кефирный гриб польза как пользоваться где купить?

Кефирные зерна

Живой кефирный тибетский гриб

Молочный гриб

Тибетский молочный гриб

Форма бактерий 5 класс биология



Поделиться фото в социальных сетях:
Комментариев (0)
Похожие фото:











